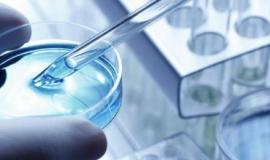

Filtre 

EuroMed Agenda
08 June 2020
Union for the Mediterranean (UfM)
05 June 2020
The Economist Events
04 June 2020
Majalat Consortium
04 June 2020
UN Global Compact Network Tunisia
03 June 2020
Organisation for Economic Co-operation and Development (OECD)
02-03 June 2020
Belgium
European Economic and Social Committee (EESC)